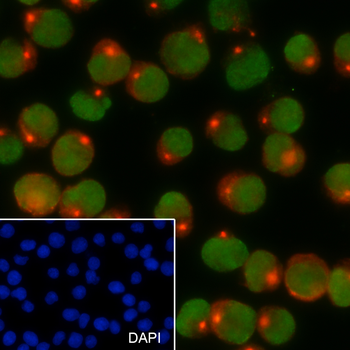

You have no items in your shopping cart.
Cart summary

SETDB1 Antibody
Catalog Number: orb193020
| Catalog Number | orb193020 |
|---|---|
| Category | Antibodies |
| Description | SETDB1 Antibody |
| Clonality | Polyclonal |
| Species/Host | Rabbit |
| Conjugation | Unconjugated |
| Reactivity | Human, Mouse, Rat |
| UniProt ID | Q15047 |
| Tested applications | IF, WB |
| Antibody Type | Primary Antibody |
| Storage | Store at -20°C for long term preservation (recommended). Store at 4°C for short term use. |
| Note | For research use only |
Anti-ESET Antibody [orb341002]
IH, WB
Human, Mouse, Rat
Rabbit
Polyclonal
Unconjugated
200 μl, 100 μl, 50 μlSETDB1 Recombinant Mouse Monoclonal Antibody [orb1172934]
ICC, IF, IHC-Fr, IHC-P, WB
Monkey, Mouse, Rat
Human
Mouse
Recombinant
Unconjugated
25 μl, 100 μl, 50 μlSETDB1 Antibody [orb631096]
ELISA, IHC, WB
Human, Mouse, Rat
Rabbit
Polyclonal
Unconjugated
100 μg, 50 μg